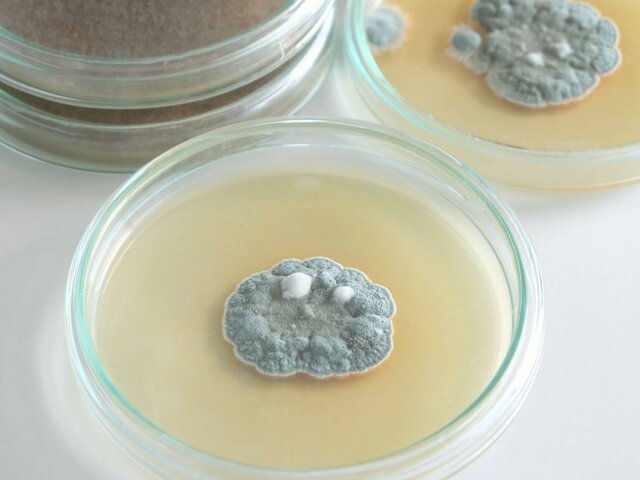
Nascita degli antibiotici

-
 inizio del neolitico
inizio del neolitico -

-

-
 È un sistema strutturale semplice, composto da tre elementi un architrave e due piedritti. Insieme a lui ci sono Stonage e La porta dei Leoni
È un sistema strutturale semplice, composto da tre elementi un architrave e due piedritti. Insieme a lui ci sono Stonage e La porta dei Leoni -
 È una struttura architettonica di forma curva che appoggia su due piedritti. Può essere di tre tipi: l'arco a tutto sesto, a volta a botte e a cupola
È una struttura architettonica di forma curva che appoggia su due piedritti. Può essere di tre tipi: l'arco a tutto sesto, a volta a botte e a cupola -
 La inventarono i Sumeri, in Mesopotamia.
La inventarono i Sumeri, in Mesopotamia. -
 La inventò un inventore cinese chiamato Cai Lun
La inventò un inventore cinese chiamato Cai Lun -
 È una struttura architettonica triangolare costruita solitamente in legno
È una struttura architettonica triangolare costruita solitamente in legno -
 È composto da tre parti ben distinte: pilastro, travi e solai
È composto da tre parti ben distinte: pilastro, travi e solai -
 Secondo Needham, la polvere da sparo fu usata per la prima volta in Cina in questo anno.
Secondo Needham, la polvere da sparo fu usata per la prima volta in Cina in questo anno. -
 È uno strumento di navigazione creato dai cinesi.
È uno strumento di navigazione creato dai cinesi. -
 La costruì Filippo Brunelleschi a Firenze, tutt'oggi è la cupola più grande al mondo.
La costruì Filippo Brunelleschi a Firenze, tutt'oggi è la cupola più grande al mondo. -
 Consideriamo questo anno come l'invenzione della stampa perchè fu pubblicata la prima Bibbia di Gutenberg.
Consideriamo questo anno come l'invenzione della stampa perchè fu pubblicata la prima Bibbia di Gutenberg. -
 Invenzione di Leonardo Da Vinci, ne esistono di due tipi.
Invenzione di Leonardo Da Vinci, ne esistono di due tipi. -
 Il carro armato di Da Vinci è uno dei primi carri armati al mondo, il progetto fu iniziato nel 1485 e il progetto si trova su due fogli di carta contenuti oggi nel British Museum.
Il carro armato di Da Vinci è uno dei primi carri armati al mondo, il progetto fu iniziato nel 1485 e il progetto si trova su due fogli di carta contenuti oggi nel British Museum. -
 In questo anno Leonardo da Vinci iniziò gli studi sul volo degli uccelli per poi creare l'ornitottero.
In questo anno Leonardo da Vinci iniziò gli studi sul volo degli uccelli per poi creare l'ornitottero. -

-
 È un invenzione di Galileo. È uno dei numerosi compassi costruiti da Galileo.
È un invenzione di Galileo. È uno dei numerosi compassi costruiti da Galileo. -
 Fu inventato da Galileo Galilei. È uno strumento che mediante il funzionamento di lenti o specchi o altri dispositivi permette la visione di oggetti spaziali lontani. Le prime lenti vennero create già nel 1907 ma il primo utilizzo fu nel 1609.
Fu inventato da Galileo Galilei. È uno strumento che mediante il funzionamento di lenti o specchi o altri dispositivi permette la visione di oggetti spaziali lontani. Le prime lenti vennero create già nel 1907 ma il primo utilizzo fu nel 1609. -
 Questa rivoluzione sostiene l'incremento della popolazione.
Questa rivoluzione sostiene l'incremento della popolazione. -
 La inventò John Kay, questa invenzione permise di accelerare il lavoro di tessitura.
La inventò John Kay, questa invenzione permise di accelerare il lavoro di tessitura. -
 Agricoltura meccanizzata e trasporti
Agricoltura meccanizzata e trasporti -
 Fu realizzata da James Hargreaves e questa consentiva ad un solo operaio di produrre più fili di cotone contemporaneamente.
Fu realizzata da James Hargreaves e questa consentiva ad un solo operaio di produrre più fili di cotone contemporaneamente. -
 Fu realizzato da Richard Arkwright, questo filatoio utilizzava l'energia dell'acqua.
Fu realizzato da Richard Arkwright, questo filatoio utilizzava l'energia dell'acqua. -
 Fu brevettata da James Watt, questa macchina fu impiegata soprattutto nell'industria tessile.
Fu brevettata da James Watt, questa macchina fu impiegata soprattutto nell'industria tessile. -
 Fu creato da Samuel Crompton, questo macchinario faceva il lavoro di 30 operai tramite uno solo di questi ma soprattutto produceva filati di miglior qualità e robustezza a prezzi inferiori.
Fu creato da Samuel Crompton, questo macchinario faceva il lavoro di 30 operai tramite uno solo di questi ma soprattutto produceva filati di miglior qualità e robustezza a prezzi inferiori. -

-
 In questo anno fu creata la ghigliottina, più precisamente nelle prime due settimane di aprile.
In questo anno fu creata la ghigliottina, più precisamente nelle prime due settimane di aprile. -
 In Inghilterra fu costruita la prima locomotiva a vapore, fu progettata da George e Robert Stephenson e andava da Liverpool a Manchester. La velocità era bassa circa 27 km/h.
In Inghilterra fu costruita la prima locomotiva a vapore, fu progettata da George e Robert Stephenson e andava da Liverpool a Manchester. La velocità era bassa circa 27 km/h. -
 nacque la prima forma di fotografia al mondo.
nacque la prima forma di fotografia al mondo. -
 Questa fu la prima linea ferroviaria in Italia, fatta costruire da Ferdinando II di Borbone e andava da Napoli a Portici, era lunga 7,25 km
Questa fu la prima linea ferroviaria in Italia, fatta costruire da Ferdinando II di Borbone e andava da Napoli a Portici, era lunga 7,25 km -
 È l'insieme di due materiali: il calcestruzzo e i tondini di ferro
È l'insieme di due materiali: il calcestruzzo e i tondini di ferro -
 Avvenne a Londra dove si costruì il Cristal palace. Il tema è l'industria di tutte le nazioni.
Avvenne a Londra dove si costruì il Cristal palace. Il tema è l'industria di tutte le nazioni. -
 l'Inglese Alexander Parkes crea e brevetta il primo materiale di plastica semisintetico.
l'Inglese Alexander Parkes crea e brevetta il primo materiale di plastica semisintetico. -
 "Grazie" all'incendio di Chicago avvenuto in questo anno bisognava ricostruire molti edifici e ne approfittarono per costruire il primo grattacielo in cemento armato.
"Grazie" all'incendio di Chicago avvenuto in questo anno bisognava ricostruire molti edifici e ne approfittarono per costruire il primo grattacielo in cemento armato. -
 Questa rivoluzione è caratterizzata da una crisi economica a fine dell'800 chiamata GRANDE DEPRESSIONE.
Questa rivoluzione è caratterizzata da una crisi economica a fine dell'800 chiamata GRANDE DEPRESSIONE. -
 In questa immagine possiamo osservare uno tra i primi telefoni inventato da Antonio Meucci
In questa immagine possiamo osservare uno tra i primi telefoni inventato da Antonio Meucci -
 Questa è la prima bicicletta costruita nella storia, fu costruita da Kirkpatrick Macmillan.
Questa è la prima bicicletta costruita nella storia, fu costruita da Kirkpatrick Macmillan. -
 La inventò Aimè Argand, noto inventore svizzero.
La inventò Aimè Argand, noto inventore svizzero. -
 Avvenne a Parigi e il tema era: celebrazione del centenario della Rivoluzione Francese
Avvenne a Parigi e il tema era: celebrazione del centenario della Rivoluzione Francese -
 In questa immagine possiamo osservare una tra le prime radio inventata da Guglielmo Marconi
In questa immagine possiamo osservare una tra le prime radio inventata da Guglielmo Marconi -
 Avvenne a Milano e il tema erano i Trasporti
Avvenne a Milano e il tema erano i Trasporti -
Alexander Fleming riuscì a caratterizzare la penicillina dando inizio all'era degli antibiotici
Alexander Fleming riuscì a caratterizzare la penicillina dando inizio all'era degli antibiotici -
 Questa è un immagine delle prima televisione ovviamente con immagini in bianco e nero
Questa è un immagine delle prima televisione ovviamente con immagini in bianco e nero -

-
 Anche se è una scoperta importante secondo me era anche meglio non farla
Anche se è una scoperta importante secondo me era anche meglio non farla -

Want to make a timeline like this?
Use Timetoast to turn dates, events, milestones, and phases into a clear visual timeline you can build and share. Timetoast is a timeline maker for work, school, research, and stories.